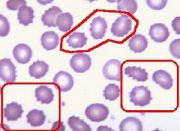

文件列表
来自医学百科
本特殊页面展示所有上传的文件。
| 日期 | 名称 | 缩略图 | 尺寸 | 用户 | 说明 | 版本 |
|---|---|---|---|---|---|---|
| 2014年1月17日 (五) 08:19 | Bk5xz.jpg (文件) | 6 KB | Admin | 1 | ||
| 2014年1月17日 (五) 08:19 | Bk75a.jpg (文件) |  |
7 KB | Admin | 1 | |
| 2014年1月17日 (五) 08:19 | Gks4tug4.jpg (文件) |  |
19 KB | Admin | 1 | |
| 2014年1月17日 (五) 08:19 | Bkcpc.jpg (文件) |  |
9 KB | Admin | 1 | |
| 2014年1月17日 (五) 08:19 | Bk8pg.jpg (文件) |  |
13 KB | Admin | 1 | |
| 2014年1月17日 (五) 08:19 | Bkkso.jpg (文件) |  |
20 KB | Admin | 1 | |
| 2014年1月17日 (五) 08:18 | Bk0gg.jpg (文件) |  |
253 KB | Admin | 1 | |
| 2014年1月17日 (五) 08:18 | Gmpzmqj3.jpg (文件) |  |
33 KB | Admin | 1 | |
| 2014年1月17日 (五) 08:18 | Bkg03.jpg (文件) |  |
37 KB | Admin | 1 | |
| 2014年1月17日 (五) 08:18 | Gp1gks55.jpg (文件) | 6 KB | Admin | 1 | ||
| 2014年1月17日 (五) 08:18 | Bk8mq.jpg (文件) |  |
5 KB | Admin | 1 | |
| 2014年1月17日 (五) 08:18 | Gum5n1mx.jpg (文件) |  |
2 KB | Admin | 1 | |
| 2014年1月17日 (五) 08:18 | Bkplh.jpg (文件) |  |
227 KB | Admin | 1 | |
| 2014年1月17日 (五) 08:17 | Bk21c.jpg (文件) |  |
48 KB | Admin | 1 | |
| 2014年1月17日 (五) 08:17 | Bkjlf.jpg (文件) |  |
3 KB | Admin | 1 | |
| 2014年1月17日 (五) 08:17 | Bk1l2.jpg (文件) |  |
22 KB | Admin | 1 | |
| 2014年1月17日 (五) 08:17 | Gmpybkap.jpg (文件) |  |
5 KB | Admin | 1 | |
| 2014年1月17日 (五) 08:17 | Bke25.jpg (文件) |  |
62 KB | Admin | 1 | |
| 2014年1月17日 (五) 08:17 | Bkdz9.jpg (文件) |  |
45 KB | Admin | 1 | |
| 2014年1月17日 (五) 08:17 | Gunqtqwv.jpg (文件) |  |
38 KB | Admin | 1 | |
| 2014年1月17日 (五) 08:17 | Bkq2f.jpg (文件) |  |
42 KB | Admin | 1 | |
| 2014年1月17日 (五) 08:16 | Bkqro.jpg (文件) |  |
36 KB | Admin | 1 | |
| 2014年1月17日 (五) 08:16 | Guqh7qoz.jpg (文件) |  |
25 KB | Admin | 1 | |
| 2014年1月17日 (五) 08:16 | Bk3vj.jpg (文件) |  |
12 KB | Admin | 1 | |
| 2014年1月17日 (五) 08:16 | Bk3n1.jpg (文件) |  |
286 KB | Admin | 1 | |
| 2014年1月17日 (五) 08:16 | Bkhyg.jpg (文件) |  |
45 KB | Admin | 1 | |
| 2014年1月17日 (五) 08:16 | Bk8zv.jpg (文件) |  |
5 KB | Admin | 1 | |
| 2014年1月17日 (五) 08:16 | Gkqe1l83.jpg (文件) |  |
16 KB | Admin | 1 | |
| 2014年1月17日 (五) 08:16 | Bkdjr.jpg (文件) |  |
42 KB | Admin | 1 | |
| 2014年1月17日 (五) 08:16 | Bkex3.jpg (文件) |  |
12 KB | Admin | 1 | |
| 2014年1月17日 (五) 08:15 | Gl0upcvp.jpg (文件) |  |
11 KB | Admin | 1 | |
| 2014年1月17日 (五) 08:15 | Bkbbc.jpg (文件) |  |
2 KB | Admin | 1 | |
| 2014年1月17日 (五) 08:15 | Bkb9z.jpg (文件) |  |
11 KB | Admin | 1 | |
| 2014年1月17日 (五) 08:15 | Guwgeniz.jpg (文件) |  |
18 KB | Admin | 1 | |
| 2014年1月17日 (五) 08:15 | Bk3lf.jpg (文件) |  |
30 KB | Admin | 1 | |
| 2014年1月17日 (五) 08:15 | Bkedk.jpg (文件) |  |
44 KB | Admin | 1 | |
| 2014年1月17日 (五) 08:15 | Bkqso.jpg (文件) |  |
64 KB | Admin | 1 | |
| 2014年1月17日 (五) 08:15 | Bk8ng.jpg (文件) |  |
3 KB | Admin | 1 | |
| 2014年1月17日 (五) 08:15 | Bklh5.jpg (文件) |  |
17 KB | Admin | 1 | |
| 2014年1月17日 (五) 08:14 | Glaqypfu.jpg (文件) |  |
29 KB | Admin | 1 | |
| 2014年1月17日 (五) 08:14 | Bkdwu.jpg (文件) |  |
477 KB | Admin | 1 | |
| 2014年1月17日 (五) 08:14 | Glysl7yf.jpg (文件) |  |
39 KB | Admin | 1 | |
| 2014年1月17日 (五) 08:14 | Bk38h.jpg (文件) |  |
5 KB | Admin | 1 | |
| 2014年1月17日 (五) 08:14 | Bklkf.jpg (文件) |  |
23 KB | Admin | 1 | |
| 2014年1月17日 (五) 08:14 | Gq0p6qzh.jpg (文件) |  |
14 KB | Admin | 1 | |
| 2014年1月17日 (五) 08:14 | Bk6yf.jpg (文件) |  |
17 KB | Admin | 1 | |
| 2014年1月17日 (五) 08:14 | Bknvq.jpg (文件) |  |
26 KB | Admin | 1 | |
| 2014年1月17日 (五) 08:14 | Bkmek.jpg (文件) |  |
4 KB | Admin | 1 | |
| 2014年1月17日 (五) 08:13 | Bkpn1.jpg (文件) |  |
42 KB | Admin | 1 | |
| 2014年1月17日 (五) 08:13 | Bk9rz.jpg (文件) | |
14 KB | Admin | 1 |